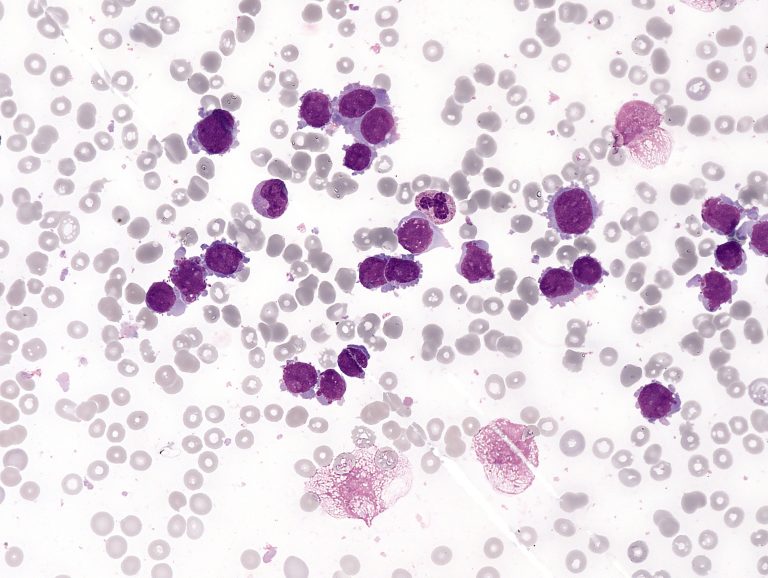
Τα καρκινικά μονοπάτια της οξείας λευχαιμίας

- Αρχική
- Κλασική Ιατρική
- Αγγειοχειρουργική
- Αιματολογία
- Ακτινοθεραπεία
- Αλλεργιολογία
- Αναισθησιολογία
- Γαστρεντερολογία
- Γηριατρική
- Γυναικολογία
- Δερματολογία
- Ενδοκρινολογία
- Ιστορία και ιατρική
- Καρδιολογία
- Καρδιοχειρουργική
- Κτηνιατρική
- Λοιμωξιολογία
- Μεταμοσχεύσεις
- Νευρολογία
- Νευροχειρουργική
- Νεφρολογία
- Ογκολογία
- Οδοντιατρική
- Ορθοπαιδική
- Ουρολογία
- Οφθαλμολογία
- Παθολογία
- Παιδιατρική
- Πλαστική Χειρουργική
- Πνευμονολογία
- Ρευματολογία
- Φυσική Ιατρική και αποκατάσταση
- Χειρουργική
- Ψυχιατρική
- Ωτορινολαρυγγολογία
- Εναλλακτικές Θεραπείες
- Ιατρικά θέματα
- Διατροφή
ΔΗΜΟΦΙΛΗ ΑΡΘΡΑ
ΤΕΛΕΥΤΑΙΑ ΑΡΘΡΑ
ΣΧΕΤΙΚΑ ΜΕ ΕΜΑΣ
Το emedi.gr είναι ένα portal στον Τομέα της υγείας. Το περιεχόμενο του emedi.gr συντάσσεται από μεγάλο αριθμό διακεκριμένων επιστημόνων αλλά και δημοσιογράφους υγείας, που προσφέρουν τις γνώσεις και την άποψή τους ανάλογα με το γνωστικό τους αντικείμενο.
Επικοινωνήστε μαζί μας: [email protected]
© Powered by iSOL.gr